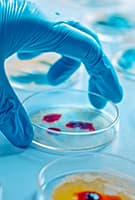

Auch wenn man es oft nicht sieht – Glas macht unser Leben leichter, schöner, umweltfreundlicher, sicherer, innovativer und besser. Von der Architektur über Medizin, Verkehrssicherheit und Mode bis hin zur Tischkultur und innovativen Forschung.
Besonders im Bereich des Umweltschutzes und der Energiewende wird Glas eine immer wichtigere Rolle spielen.
Dabei ist Glas besonders nachhaltig: Es besteht nicht nur zu 100 % aus natürlichen Rohstoffen, sondern ist vollständig und unbegrenzt oft recycelbar.
Das alles macht Glas zu einem Werkstoff, der unsere Zukunft lebenswerter macht.
In Österreich werden pro Jahr über 266.000 Tonnen Glas recycelt. So werden aus Abfall wertvolle Rohstoffe, die unbegrenzt und unendlich oft recycelbar sind. Und das ohne Qualitätsverlust. Damit trägt Glas wie kein anderer Werkstoff zur nachhaltigen Kreislaufwirtschaft bei.
Das vermeidet nicht nur Müll und schont Ressourcen, sondern spart auch Energie: Denn Altglas lässt sich mit weniger Energie einschmelzen als die natürlichen Primärrohstoffe Quarzsand, Kalk, Soda und Dolomit. Dabei werden 30% Energie und 70% CO2-Emissionen eingespart.
Und mit der Entwicklung von Leichtglasbehältern trägt die Glasindustrie zusätzlich zur Ressourcenschonung und CO2-Reduktion bei. Denn Leichtglas weist trotz wesentlich geringerem Materialverbrauch die gleiche Stabilität wie schwerere Vorgängermodelle auf.
Glas hilft uns beim schnellen Ausstieg aus Öl, Gas und Kohle. Mit Dämmwolle, dreifach isolierten Fensterscheiben oder innovativen Verglasungen hilft es beim Energiesparen. Und sorgt auch für die Gewinnung erneuerbarer Energien – mit Solarpaneelen oder glasfaserverstärkten Windrädern.
Moderne Verglasungen, Isoliergläser und Dämmwolle mit Glasfasern steigern die Energieeffizienz von Gebäuden und reduzieren so die CO2-Emissionen. Und smarte Fenster können dabei sogar Energie gewinnen.
So wie Solarpaneele, die eine entscheidende Rolle bei der Energiewende spielen werden. Ebenso wie Windräder, deren mit Glasfaser verstärkte Rotoren sauberen Strom liefern.
Mit Glas schmeckt das Leben doppelt gut. Denn Lebensmittel und Getränke in Glasflaschen und -behältern behalten ihren vollen, ursprünglichen Geschmack. Und stilvolle Weingläser und Karaffen geben der Tischkultur schon seit jeher den letzten Schliff.
Glasverpackungen sind nicht nur geruchs- und geschmacksneutral, sondern sind inert, das heißt es findet keine Wechselwirkung zwischen dem wertvollen Inhalt und der Glasverpackung statt.
Edle Gläser und Karaffen lassen Getränke ihre besondere Geschmacksnote entfalten und sorgen dafür, dass die Aromen am besten zur Geltung kommen.
Und hitzebeständiges Glas hilft bei der perfekten Zubereitung der Speisen – in Herdtüren, als Ceran-Feld, Gratin Form oder simpler Topfdeckel.
Glas spielt in der Architektur eine zentrale Rolle. Großformatige Glasfassaden prägen moderne Gebäude und erfüllen neben Wärmedämmung und Sonnenschutz immer neue innovative Funktionen: Fenster werden smart und können darüber hinaus Energie produzieren.
Glas muss heutzutage nicht nur architektonischen und ästhetischen Ansprüchen entsprechen, sondern übernimmt auch unverzichtbare Aufgaben wie Brand-, Lärm- und Sonnenschutz.
Außerdem tragen großformatige Glasfassaden moderner Gebäude zum Klimaschutz bei: Sie verbessern die Energieeffizienz von Gebäuden und reduzieren somit CO2-Emissionen.
Dabei erfüllt Glas immer neue innovative Funktionen, die weit über die ursprüngliche Aufgaben des Schutzes und der Transparenz hinausgehen: Fenster werden smart und können darüber hinaus Energie produzieren. Manche Gläser benötigen lediglich Regen und Tageslicht, um sich selbst zu reinigen. Spezialgläser mit Touchfunktion übernehmen Kommunikationsaufgaben.
Außerdem bietet Glas unendlich viele Möglichkeiten, Arbeits- und Wohnräume zu gestalten. Es kann beschichtet, gehärtet, laminiert, durch Sandstrahlen und mit Siebdruck veredelt werden. Und trägt somit wesentlich dazu bei, unser Leben zu bereichern.
Glas leistet einen wichtigen Beitrag zu unserer Gesundheit: Es ist die beste Verpackung für Arzneimittel, spielt auch eine wichtige Rolle in der Medizintechnik und ist außerdem ein optimaler Werkstoff für Implantate – etwa in der Zahnmedizin.
Glasverpackungen schützen Arzneimittel wie ein Tresor vor äußeren Einflüssen wie Oxidation, Lichteinwirkung oder Keimen. Außerdem gibt Gals als inertes Material keine Substanzen an den Füllinhalt ab. Darum ist Glas das einzige Verpackungsmaterial, welches von der US-Lebensmittelaufsicht FDA als „grundsätzlich sicher“ (Generally Recognized As Safe – GRAS) eingestuft wird.
Von Laborausstattungen bis hin zu High-Tech-Anwendungen – Glas ist auch in der Medizintechnik nicht wegzudenken.
Zudem ist Glas auch für Knochenimplantate bestens geeignet. Denn es enthält nur Stoffe, die auch im menschlichen Körper vorkommen – Silizium, Calcium, Natrium und Phosphat. Die Abstoßreaktionen sind daher deutlich geringer als bei anderen Implantantmaterialien.
Glas lässt unser Leben glitzern. Denn als vielfältiger, universaler Werkstoff regt es Designer:innen, Innenarchitekt:innen und Künstler:innen zu immer neuen Ideen an:
Von Schmuckstücken, Textilapplikationen und trendigen Sonnenbrillen über Möbel, Leuchten und Aquarien bis zu extravagant gestalteten Flaschen für ihren Lieblingsduft.
Denn Glas erlaubt nicht nur wunderbare Designs, sondern ist wegen seiner Gasdichtheit auch das optimale Material, um flüchtige Düfte dauerhaft zu konservieren.
Mit Glas kommen wir sicher von A nach B. Nicht nur dank der Verbundglasscheiben in Autos, Zügen und Flugzeugen. Oder der Schweinwerfer und Straßenlampen. Glas steckt auch da, wo es keiner vermutet: Etwa in reflektierenden Zebrastreifen und Leitlinien.
Und Glas hilft auch mit, dank modernster Technologie den Verkehr sicherer und reibungsloser zu gestalten: Man denke nur an Touchscreens und Head-up-Displays in Fahrzeugen und Glasfaserleitungen, die in Verkehrsleitsystemen für blitzschnellen Datentransport sorgen.
Der Werkstoff Glas sichert unsere Zukunft: Er ist integraler Bestandteil innovativer Techniken, die unser aller Leben besser machen: Sei es in der Kommunikation, im Umweltschutz, in der Medizin oder in der Architektur.
Glasfaserleitungen sorgen für Breitband-Datentransfer in Lichtgeschwindigkeit. Touchscreens und Augmented Reality Brillen sorgen für immer interaktivere Kommunikationslösungen.
Smarte, selbstreinigende Glasfronten steigern die Energieeffizienz von Gebäuden und senken CO2-Emissionen.
Und Glas findet auch in der Medizin immer mehr Anwendungen – sei es in High-Tech-Geräten oder als Knochenimplantat.
Glas ist überall in unserem Leben. Darum ist die Glasindustrie genauso vielfältig wie die Berufe, die sie bietet.
Die Glasindustrie beschäftigt schon heute über 6.300 Mitarbeiter:innen. Und offeriert all jenen eine sichere Zukunft, die sich für Glas begeistern können – und bietet mit dem Lehrberuf „Glasverfahrenstechnik“ eine spannende Zukunftsperspektive.
Wenn’s um Kunst und Kultur geht - Glas ist immer mit dabei. Glas dient vielen Künstler:innen als inspirierender Werkstoff: Vom Mosaik bis hin zu interaktiven Kunstprojekten mittels Touchscreen.
Außerdem hilft Glas, Kultur zu vermitteln und ihr den passenden Rahmen zu geben – sei es als Prachtluster in Theatern und Opernhäusern, als Scheinwerfer-Batterien auf Rock- und Jazzbühnen, als Glasvitrine in Museen oder durch Glasrahmen zuhause.